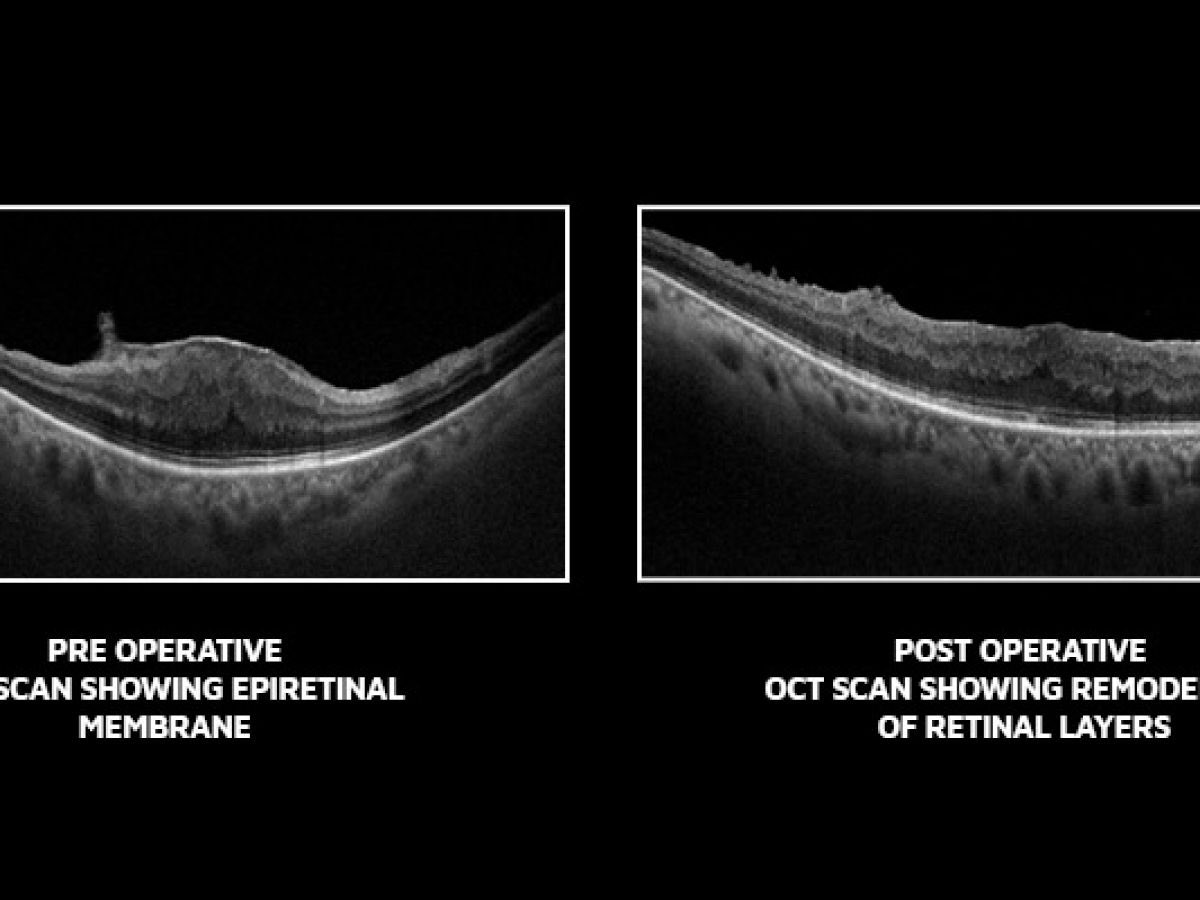

غشاء فوق #الشبكية
ثريد بسيط، معلومات اساسية، التشخيص، وهل يحتاج لعلاج جراحي في كل الحالات ؟
#صوت_الطبيب
ثريد بسيط، معلومات اساسية، التشخيص، وهل يحتاج لعلاج جراحي في كل الحالات ؟
#صوت_الطبيب
2️⃣ المسببات
في غالب الحالات يكون بدون سبب واضح، بعض المسببات الثانوية
- السكري
- التهابات عنبية العين
- عمليات جراحية في العين
- انفصال شبكية
في غالب الحالات يكون بدون سبب واضح، بعض المسببات الثانوية
- السكري
- التهابات عنبية العين
- عمليات جراحية في العين
- انفصال شبكية
3️⃣ الفئة العمرية
متوسّط العمر للاصابة باغشية فوق الشبكية ٦٥ سنة (مع العلم انه قد يصيب اي فئة عمرية)
معدل الحالات السنوي ١.١٪
متوسّط العمر للاصابة باغشية فوق الشبكية ٦٥ سنة (مع العلم انه قد يصيب اي فئة عمرية)
معدل الحالات السنوي ١.١٪
5️⃣ العلاج
اولاً
لاتعالج اغشية فوق الشبكية الا في حالة تأثيرها على الابصار وبالتالي جودة حياة المراجع، و(القفز) الى العلاج بدون التأكد من مدى تأثيرها على الابصار يعتبر اجراء غير سليم
اولاً
لاتعالج اغشية فوق الشبكية الا في حالة تأثيرها على الابصار وبالتالي جودة حياة المراجع، و(القفز) الى العلاج بدون التأكد من مدى تأثيرها على الابصار يعتبر اجراء غير سليم
نستقبل اي اسئلة عن هذا الموضوع او اي سؤال في العيون على العام،
بالسلامة للجميع 💐
بالسلامة للجميع 💐
جاري تحميل الاقتراحات...